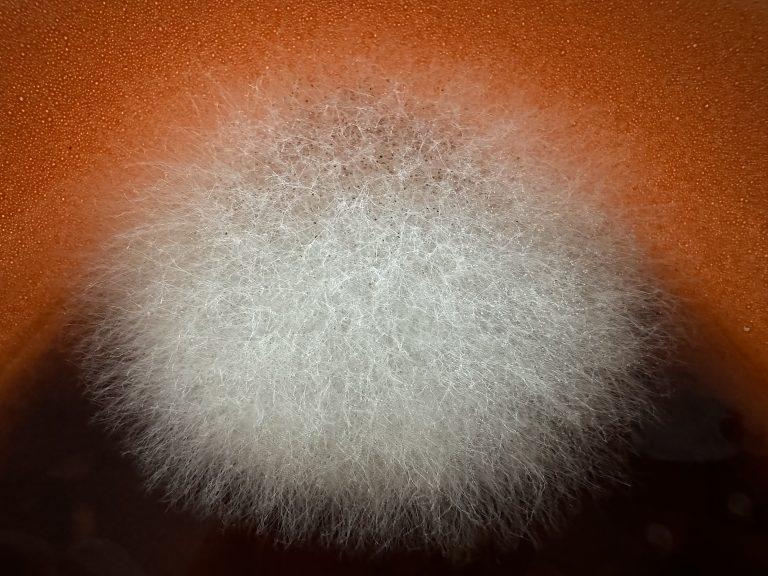

Presse Termin
München
Poems-Terminal Munich
Klick-Tipps

15.11.18: Remember Midterms Tag 8
KARI LAKE VERLIERT GEGEN KATIE HOBS
Sieht aus, wie’s gute (?) Sitte
Als tendierte DSA* leicht zur Mitte<br
14.11.24 Übergang: Amt + 3 Häuser
14.11.24 Biden übergibt (sich…)
DSA*: 3 Häuser von der LOP* beherrscht
Präsident D.J. Trump ist ein Mann

14.11.22: Remember Midterms: Buchtipp
NEW YORK TIMES BESTSELLER • The vital inside account of American democracy in its darkest hour, from the rise of

2024 Reichert November Press-Day
2024 REICHERT PRESS DAY
Reichert+Communications machte am 5.11.24 den traditionellen Herbst-Besuch in München, im Hotel The Charles. Eine gute

13.11.24 Den Senat umgehen
13.11.24 SENAT UNBEQUEM
Fragst du erst lang den Senat
hast Du meistens den Salat!!
Ich will gar

13.11.22: Remember Midterms Tag 6
SENATS-MEHRHEIT VERTEIDIGT!
Uff!! Der Senat ist neu gewichtet
Nevadas Senatorin* hat’s gerichtet
Wahlbetrug, hört man es flüstern<br
06.11.2024
Donald John TRUMP
47th President of DSA* GOP**
from „The Apprentice“
to The Master of Disaster
*Divided States of America
**Greedy Old Party
🇩🇪 Hinweis: Alle Bilder auf diesem Blog wurden mit KI erstellt – also nicht von echten Kameras, sondern von einer Maschine, die weiß, wie man’s lustig übertreibt. Sie zeigen satirische Darstellungen und sind nicht als echte Fotos oder Aussagen zu verstehen. Wenn hier bekannte Personen auftau-chen: Keine Sorge – das ist keine Ver-leumdung, sondern Meinung mit Au-genzwinkern.
🇬🇧 Disclaimer: All images on this blog were created using AI tools (ChatGPT/ DALL·E) and are meant for satire and commentary. They are not real photos or factual depictions. Any resemblance to real people – especially public figures – is intentional but exaggerated for comedic or critical effect. It’s all part of free speech and good old-fashioned political satire.
Kalenderblatt
Samstag 11.1.25
Kalenderblatt Samstag, 11. Januar 2025 Zitat des Tages: „In der Politik ist es wie in der Elektrizität: Wo es Kontakte gibt, gibt es auch Spannungen.“
Freitag 10.1.25
Kalenderblatt Freitag, 10. Januar 2025 Zitat des Tages: „Die allermutigste Handlung ist immer noch, selbst zu denken. Laut.“ Coco Chanel (1883-1971) 10.1.1971: Coco Chanel: Ein





